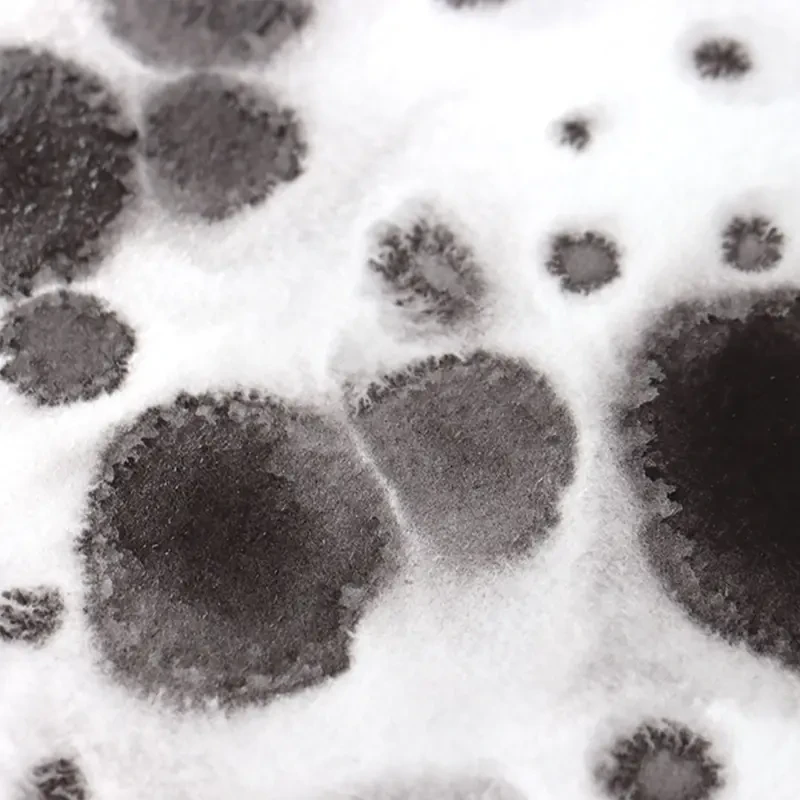
Farba akwarelowa Białe Noce kostka - 838 Chromium Irone Oxide 04

Farba akwarelowa Białe Noce kostka - 838 Chromium Irone Oxide
Cena regularna:
towar niedostępny
Akwarela White Nights
Akwarele Białe Noce (White Nights) to profesjonalne rosyjskie farby wodne produkowane przez firmę Nevskya Palitra, które składają się z drobno zmielonych, skoncentrowanych pigmentów, dzięki którym oferują świetliste, intensywne, transparentne kolory. Dzięki dodatkowi gumy arabskiej z żywicy akacjowej, farby akwarelowe Białe Noce nie pękają i są wysoce światłoodporne, dzięki czemu wykonane nimi prace nie blakną przez długie lata.
Farby akwarelowe Białe Noce zdobyły światową sławę dzięki swojej niepowtarzalnej jakości. Wysokiej jakości pigmenty są połączone z wypełniaczami w spoiwie zawierającym wodny roztwór gumy arabskiej, dekstrynu, plastyfikatora, środków zmniejszających napięcie powierzchniowe i środków antyseptycznych. Akwarele Białe Noce łatwo rozprowadzają się po powierzchni papieru, zachowując intensywny kolor nawet przy użyciu dużej ilości wody.
838 Cromium Irone Oxide ***◨△G - kolor granulujący
Granulacją farb akwarelowych nazywamy efekt ziarnistej tekstury wywołany nieregularnie osadzającymi się na papierze cząsteczkami pigmentu. Akwareliści wykorzystują to do malowania nierównych powierzchni, np. skał, piasku czy drewna, ale też do nieba oraz abstrakcji. Rodzaj użytego papieru wpływa na intensywność efektu granulacji; użycie papieru akwarelowego o wyraźnej fakturze (rough lub torchon) znacznie zwiększa jego intensywność.
Rozmiar kostki około: 26 x 15 x 10 mm
Oznaczenia:
zmywalność: ▲ barwiące | △ nieplamiące | ◮ półplamiące
krycie: ■ nieprzezroczysty | □ przezroczysty | ◨ półprzezroczysty
odporność na światło: *** wysoka | ** średnia | * niska
G - farba granulująca

・Kup teraz i zapłać za 30 dni
・Kup teraz i zapłać za 30 dni





























Nie ma jeszcze żadnych opinii, bądź pierwszy!